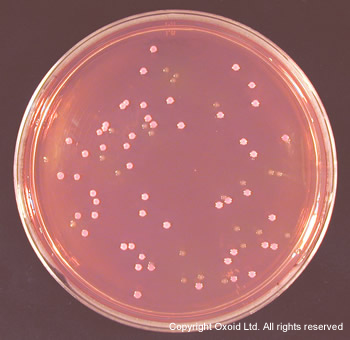
Oxoid山梨醇麦康凯琼脂CM0813B,CM0981B,改

相关产品推荐更多 >
万千商家帮你免费找货
0 人在求购买到急需产品
- 详细信息
- 技术资料
- 库存:
99
- 供应商:
北京云肽生物科技有限公司
Oxoid山梨醇麦康凯琼脂CM0813B,CM0981B,改良TSB CM0989B,EC肉汤CM0853B等
英国Oxoid于1924年成立,现属于知名的Thermo Fisher Scientific集团一员,目前为领先全球的微生物培养基制造商与诊断试剂销售商。公司总部位于英国贝星斯托克(Basingstoke),产品销售遍及欧盟各国、美洲与澳洲,另外也委托世界各地专业的微生物产品代理商经营国际Oxoid事业。Oxoid产品范围阔及与疾病、微生物诊断相关的临床检验科学、基础学术研究与工业生产领域。英国Oxoid是世界上第二大微生物相关产品的生产商,总部设在英格兰Basingstoke,在全球14个国家设有分公司,并在62个国家和地区设有经授权的代理商。Oxoid培养基、微生物培养、诊断试剂、生化鉴定、药敏纸锭。
我们北京云肽生物科技有限公司作为Oxoid公司的特约经销商为客户提供,保证原装正品,货期稳定,折扣好的服务标准。
Oxoid山梨醇麦康凯琼脂CM0813B,CM0981B,改良TSB CM0989B,EC肉汤CM0853B等,产品简介:
产品品牌:Oxoid
产品名称:山梨醇麦康凯琼脂CM0813B,CM0981B,改良TSB CM0989B,EC肉汤CM0853B等
产品货号:CM0813B/CM0981B/CM0989B/CM0853B
产品规格:500g
产品说明:
大肠杆菌O157的培养基:
山梨醇麦康凯琼脂 CM0813B
山梨醇麦康凯琼脂(含BCIG) CM0981B
EC肉汤(减少胆盐) CM0990B
改良胰蛋白胨大豆肉汤 CM0989B
头孢克肟鼠李糖山梨醇麦康凯琼脂 CM1005B
EC肉汤 CM0853B
EC肉汤(含MUG) CM0979B
干粉培养基10-30℃保存
山梨醇麦康凯琼脂 (Sorbitol MacConkey Agar)
培养大肠杆菌O157的选择性培养基
| 货号 | 产品描述 | 规格 | 可配制培养基 |
| CM0813B | 山梨醇麦康凯琼脂 Sorbitol MacConkey Agar 用于检测大肠杆菌O157的选择性和鉴别培养基,可添加C-T添加剂增加选择性 |
500g | 9.7L |
| CM0813R | 2.5kg | 48.5L | |
| CM0813K | 25kg | ||
| SR0172E | C-T添加剂,Cefixime-Tellurite Supplement 0℃以下保存,与CM0813一起配制成:头孢克肟亚碲酸盐山梨醇麦康凯琼脂 |
10小瓶 | 每小瓶配500ml |
| SR0172H | 10小瓶 | 每小瓶2.0L | |
| CM0981A | 山梨醇麦康凯琼脂(含BCIG) Sorbitol MacConkey Agar with BCIG 用于检测大肠杆菌O157的选择性和鉴别培养基, 含有BCIG产色剂,再加入C-T添加剂SR0172一起使用 |
100g | 1.94L |
| CM0981B | 500g | 9.7L | |
| CM1005B | 头孢克肟鼠李糖山梨醇麦康凯琼脂基础 Cefixime Rhamnose Sorbitol MacConkey Agar Base 用于分离大肠杆菌O157的选择性和鉴别培养基, 添加头孢克肟添加剂SR0191E组成头孢克肟鼠李糖山梨醇麦康凯琼脂 |
500g | 8.8L |
| SR0191E | 头孢克肟添加剂 Cefixime Supplement | 10小瓶 | 每小瓶500ml |
山梨醇麦康凯琼脂 CM0813
配方表:
| 成分* | 含量 g/L |
| 蛋白胨 | 20.0 |
| 山梨醇 | 10.0 |
| 3号胆盐 | 1.5 |
| *化钠 | 5.0 |
| 酚红 | 0.03 |
| 结晶紫 | 0.001 |
| 琼脂 | 15.0 |
| pH 7.1±0.2 @25℃ |
C-T添加剂 SR0172E
| 成分 | 每小瓶含 | 每升培养基含 |
| 亚碲酸钾 | 1.25mg | 2.5mg |
| 头孢克肟 | 0.025mg | 0.05mg |
制备方法:
取51.5g培养基至1L蒸馏水中,煮沸至完全溶解,121℃高压灭菌15分钟,冷却至50℃,混匀倒入无菌培养皿。
如果需要的话,根据SR0172的产品说明进行溶解,每500ml培养基加入1瓶SR0172E,加入冷却后的培养基中,混匀后再倒平板。
产品描述:
大肠杆菌O157被认为是出血性结肠炎的一个病因,是出血性腹泻、严重的腹部疼痛、溶血性尿毒症的病理特征菌。因此,它是一个特别重要的人病原体。
山梨醇麦康凯琼脂可以用来提取病理大肠杆菌O157.它的配方是由Rappaport and Henig的描述基础上而来,是根据3号麦康凯琼脂改变的,将其中的乳糖变为了山梨醇。大肠杆菌O157不发酵山梨醇,因此产生无色菌落。相比之下,大部分的大肠杆菌发酵山梨醇,形成粉色菌落。山梨醇麦康凯琼脂的有效性被March and Ratnam做过确认实验,他们的文章得出100%的灵敏度和85%的特异性,所以认为这款培养基是一款简单地,不昂贵的,快速的,可信的大肠杆菌O157的筛选培养基。
Chapman等人在山梨醇麦康凯琼脂中添加头孢克肟和亚碲酸钾,以增加培养基的选择性。这种浓度的亚碲酸钾将O157血清型与其他血清型区分出来,并抑制普罗威登斯菌和嗜水气单胞菌,头孢克肟抑制变形杆菌属。
在山梨醇麦康凯琼脂中添加头孢克肟和亚锑酸钾的方法再FDA 细菌学分析手册中有描述。
培养基35℃培养24小时,避免过长时间的培养。
可使用大肠杆菌O157乳胶凝集试剂盒DR0620,来快速鉴定可疑的O157菌落。
保存:
干粉培养基10-30℃保存,SR0172在0℃以下保存,效期之前使用。制成培养基在2-8℃保存,避免光的照射,最多保存2周。
山梨醇麦康凯琼脂(含BCIG) CM0981
含有5-*-4-*-3-吲哚-β-D-葡萄糖苷酸(BCIG)
配方表:
| 成分* | 含量 g/L |
| 蛋白胨 | 20.0 |
| 山梨醇 | 10.0 |
| 3号胆盐 | 1.5 |
| *化钠 | 5.0 |
| 酚红 | 0.03 |
| 结晶紫 | 0.001 |
| 琼脂 | 15.0 |
| 5-bromo-4-chloro-3-indolyl-b-D-glucuronide(BCIG) | 0.1 |
| pH 7.1±0.2 @25℃ |
制备方法:
取51.6g培养基至1L蒸馏水中,混匀,121℃高压灭菌15分钟,混匀倒入无菌培养皿。
产品描述:
含有BCIG的山梨醇麦康凯琼脂(SMAC)含有两种大肠杆菌O157的选择性因子:对山梨醇的不发酵,β-葡萄糖苷酶的活性的出现。在一次对人工污染的肉类样品的测试中,含有BCIG的SMAC将大肠杆菌O157的失败检出的概率下降了36%。
这款培养基中的5-*-4-*-3-吲哚-β-D-葡萄糖苷酸(BCIG)是β-葡萄糖苷酶的底物,这种酶并不在O157大肠杆菌中常见。非发酵山梨醇,以及β-葡萄糖苷酶阴性的大肠杆菌O157生成麦色菌落。具有β-葡萄糖苷酶的微生物将分解BCIG底物,形成吲哚酚(或卤代酚),迅速形成不溶性染料或其类似物,导致明显的蓝绿色菌落。
在35-37℃培养24小时,查看麦色菌落,可以使用大肠杆菌O157乳胶凝集试剂盒DR0620或DR0102对可疑菌落进行确认。
大肠杆菌O157一般不发酵山梨醇,并且是β-葡萄糖苷酶阴性,因此形成无色菌落。大部分大肠杆菌其他血清型是β-葡萄糖苷酶阳性,可以发酵山梨醇,因此出现蓝色至紫色菌落。
如果高含量的革兰氏阴性菌需要被抑制,可以加入Cefixime-Tellurite (CT) Selective Supplement SR0172增加选择性。
SMAC with BCIG是一种 USDA/FSIS 认可的培养基,用来预鉴定Escherichia coli O157:H7/NM
质控菌株:
Escherichia coli O157:H7 (glucuronidase-negative) NCTC12900生长良好,无色菌落
Escherichia coli (glucuronidase-positive) ATCC® 25922生长良好,蓝色/紫色菌落
Enterococcus faecalis ATCC® 19433 被抑制
头孢克肟鼠李糖山梨醇麦康凯琼脂基础 CM1005
CR-SAMC Agar Base,与SR0191E配成CR-SAMC Agar
配方表:
| 成分* | 含量 g/L |
| 蛋白胨 | 20.0 |
| 山梨醇 | 10.0 |
| 3号胆盐 | 1.5 |
| *化钠 | 5.0 |
| 鼠李糖 | 5.0 |
| 酚红 | 0.03 |
| 结晶紫 | 0.001 |
| 琼脂 | 15.0 |
| pH 7.1±0.2 @25℃ |
SR0191E:每小瓶含0.025mg头孢克肟,在每升培养基中加入0.05mg头孢克肟。
制备方法:
取28.25g培养基至500ml蒸馏水中,混匀后121℃高压灭菌15分钟。冷却到50℃,加入已经按照说明书溶解的1瓶SR0191E(每小瓶加入2ml无菌水),混匀后倒平板。
产品描述:
在山梨醇麦康凯琼脂SMAC中加入鼠李糖,增加了大肠杆菌O157在背景菌种的区分度。大约60%的不发酵山梨醇的大肠杆菌血清型(O157血清型除外)会发酵鼠李糖。头孢克肟的存在降低了竞争菌的数量,特别是变形杆菌属,它在非山梨醇发酵菌中经常占了很大的比重。
大肠杆菌O157一般不发酵山梨醇和鼠李糖,所以产生麦色菌落。但是,大部分不发酵山梨醇的其他血清型大肠杆菌发酵鼠李糖,这些菌落为红色或粉色。
CR-SCAM与选择性更强的CT-SACM联用,可以使增菌肉汤中的大肠杆菌O157的恢复率更高。
培养基在35-37℃培养24小时
改良胰蛋白胨大豆肉汤 (Tryptone Soya Broth Modified, mTS)
用于培养大肠杆菌O157的选择性增菌肉汤,可以添加合适的添加剂增加选择性
| 货号 | 产品描述 | 规格 | 可配制培养基 |
| CM0989B | 改良胰蛋白胨大豆肉汤基础 Modified Tryptone Soya Broth (mTSB)Base 可添加SR0181E增加选择性 |
500g | 15.2L |
| SR0181E | 新生霉素添加剂 Novobiocin Supplement | 10小瓶 | 每小瓶配500ml |
| SR0190A | VCC选择性添加剂 VCC Selective Supplement | 10下小瓶 | 每小瓶225ml |
改良胰蛋白胨大豆肉汤基础 CM0989
配方表:
| 成分* | 含量 g/L |
| 酪蛋白胰酶消化物 | 17.0 |
| 大豆粉木瓜酶消化物 | 3.0 |
| *化钠 | 5.0 |
| 磷酸氢二钾 | 4.0 |
| 葡萄糖 | 2.5 |
| 胆盐 | 1.5 |
| pH 7.4±0.2 @25℃ |
SR0190A VCC选择性添加剂:
| 成分 | 每瓶含 | 每900ml培养基含 | 每升培养基含 |
| 万古霉素 | 1.8mg | 7.2mg | 8.0mg |
| 头孢克肟 | 0.01125mg | 0.045mg | 0.05mg |
| 头孢磺啶 | 2.25mg | 9.0mg | 10.0mg |
制备方法:
取33g改良TSB至1L蒸馏水中,混匀,分装支最终容器中,121℃高压灭菌15分钟,冷却至50℃后添加所需的添加剂。
产品描述:
mTSB是一种营养丰富的选择性肉汤基础,可以37℃震荡培养24小时,也有人43℃搅拌培养,使食品样品中的恢复率更佳。
缓冲蛋白胨水CM0509,添加SR0190,用来从牛肉的尸体,牛的粪便和牛奶和碎牛肉中提取大肠杆菌O157;
由SR0190E添加到CM0989中,组成EHEC enrichment broth (EEB),克服了有些大肠杆菌O157的抗生素抗性。
Both BPW-VCC (CM0509+SR0190) and EEB (CM0989+SR0190) are incubated for 6hr at 37°C
Tryptone Soya Broth (CM0129)可以通过增加一些成分变为CM0989,添加4g/L的磷酸二氢钾,以及1.5g/L的胆盐。胆盐抑制孢子和肠球菌属,但能使大肠杆菌O157生长。VCC选择性添加剂含有三种抗生素,万古霉素抑制革兰氏阳性菌,头孢克肟抑制变形杆菌,头孢磺啶抑制假单胞菌。
EC 肉汤 (EC Broth)
| 货号 | 产品描述 | 规格 | 可配制培养基 |
| CM0853B | EC肉汤,EC Broth 分离大肠杆菌和其他大肠菌群选择性肉汤 |
500g | 13.5L |
| CM0979A | EC肉汤(含MUG),EC Broth with MUG 从食品和环境样品中分离和筛选大肠杆菌和肠杆菌 |
100g | 2.7L |
| CM0979B | 500g | 13.5L | |
| CM0990B | EC肉汤(减少胆盐),EC Broth (Reduced Bile Sales) 用于培养食品和环境标本中大肠杆菌O157的选择性增菌肉汤, 可添加新生霉素增加选择性 |
500g | 13.7L |
| CM0990R | 2.5kg | 68.5L | |
| SR0181E | 新生霉素添加剂 Novobiocin Supplement | 10小瓶 | 每小瓶500ml |
EC肉汤 CM0853
配方表:
| 成分* | 含量 g/L |
| 胰蛋白胨 | 20.0 |
| 乳糖 | 5.0 |
| 3号胆盐 | 1.5 |
| 磷酸二钾 | 4.0 |
| 磷酸钾 | 1.5 |
| **钠 | 5.0 |
| pH 6.9±0.2 @25℃ |
制备方法:
取37g培养基至1L蒸馏水中,分装至最终容器中,121℃高压灭菌15分钟。
产品描述:
EC肉汤用于食品和环境中大肠杆菌的筛选。也适用于牛奶和奶制品中大肠杆菌的计数。
大肠杆菌普遍存在于食品和环境中,为革兰氏阴性菌。大肠杆菌可用来指示粪便的污染,虽然一定的摄取量无害,然而,某些菌株可导致腹泻,甚至可引起更严重的疾病。
大肠杆菌的分离鉴定利用大肠杆菌在44-45.5℃的条件下培养24-48小时乳糖被降解产气,培养温度取决于培养方法或者样本来源:
贝类 44.5℃
牛奶和牛制品44.0℃
水和污水 44.5℃
其他食物 45.5℃
EC 肉汤中含有乳糖缓冲肉汤和胆盐3 号。胆盐的存在能够抑制孢子和肠球菌的生长,但是大肠杆菌能够生长。
制成培养基最多保存4周。
EC肉汤(含MUG) CM0979
配方表:
| 成分* | 含量 g/L |
| 胰蛋白胨 | 20.0 |
| 乳糖 | 5.0 |
| 3号胆盐 | 1.5 |
| 磷酸二钾 | 4.0 |
| 磷酸钾 | 1.5 |
| **钠 | 5.0 |
| 4-methylumbelliferyl-ß-D-glucuronide (MUG) | 0.05 |
| pH 6.9±0.2 @25℃ |
制备方法:
取37g培养基至1L蒸馏水中,分装至含有杜氏小管的最终容器中,121℃高压灭菌15分钟。
产品描述:
β-葡萄糖苷酶是大肠杆菌的高度特异性的酶,研究表明90%的从环境中分离的大肠杆菌是β-葡萄糖苷酶阳性。这款培养基中添加的高度灵敏的底物4-methylumbelliferyl-ß-D-glucuronide (MUG)与β-葡萄糖苷酶反应,生成4-methylumbelliferone ,在366nm紫外下显绿色/蓝色荧光。
含有MUG的EC肉汤是被FDA/BAM认可的培养方法,用于从贝类和肉类中确认大肠杆菌。
注意事项:
确保使用的玻璃容器不会产生荧光,正确使用紫外灯以确保安全。
一些病原菌,特别是大肠杆菌O157:H7一般是葡萄糖苷酶阴性,在这种测试中会产生不正确的结果。
其他肠杆菌比如变形杆菌也葡萄糖苷酶阳性。
EC肉汤(减少胆盐) CM0990
配方表:
| 成分* | 含量 g/L |
| 胰蛋白胨 | 20.0 |
| 乳糖 | 5.0 |
| 3号胆盐 | 1.12 |
| 磷酸二钾 | 4.0 |
| 磷酸钾 | 1.5 |
| **钠 | 5.0 |
| pH 6.9±0.2 @25℃ |
制备方法:
取18.3g培养基至500ml蒸馏水中,121℃高压灭菌15分钟。冷却到50℃添加已经按照说明书溶解的1小瓶SR0181E。
产品描述:
新生霉素可以抑制革兰氏阳性菌,比如金黄色葡萄球jun(包括耐甲氧西林的),以及其他葡萄球菌。有一些革兰氏阴性菌包括流血嗜血杆菌,奈瑟氏菌,一些变形杆菌也同样对新生霉素敏感,但是大部分肠杆菌对新生霉素耐受。
EC肉汤(减少胆盐)可以对食品和环境样品中,特别是冰冻样品中的大肠杆菌O157进行增菌培养。添加新生霉素SR0181E可以增加选择性。培养基中这种浓度的胆盐可以抑制孢子和肠球菌,但是不影响大肠杆菌O157的生长,在37℃时。新生霉素的添加量是20mg/L。

以下是Oxoid品牌部分产品订购信息,如需其他产品请咨询本店客服
| 货号 | 产品名称 | 规格 |
| CM1031A | MLGA | 100g |
| CM1031B | MLGA | 500g |
| CM1032B | HEART INFUSION BROTH | 500g |
| CM1032T | HEART INFUSION BROTH | 5kg |
| CM1033B | SHIGELLA BROTH | 500g |
| CM1036A | CHROMOGENIC BACILLUS CEREUS AGAR BASE | 100g |
| CM1036B | CHROMOGENIC BACILLUS CEREUS AGAR BASE | 500g |
| CM1038B | DIFFERENTIAL COLIFORM AGAR 500g | 500g |
| CM1046B | SELECT. E.COLI/COLIFORM CHROMOGENIC MED | 500g |
| CM1048B | MKTTN BROTH BASE (ISO) | 500g |
| CM1049B | BUFFERED PEPTONE WATER (ISO) | 500g |
| CM1049R | BUFFERED PEPTONE WATER (ISO) | 2.5kg |
| CM1049T | BUFFERED PEPTONE WATER (ISO) | 5kg |
| CM1050A | CHROMOGENIC UTI MEDIUM (CLEAR) | 100g |
| CM1050B | CHROMOGENIC UTI MEDIUM (CLEAR) | 500g |
| CM1053B | DEMI-FRASER BROTH(W/O FERRIC AMMON CITR) | 500g |
| CM1053G | DEMI-FRASER BROTH w/o F.O.C. 10kg | 10kg |
| CM1053R | DEMI-FRASER BROTH(W/O FERRIC AMMON CITR) | 2.5kg |
| CM1054B | UVM 1 BROTH (COMPLETE) | 500g |
| CM1054R | UVM 1 BROTH (COMPLETE) | 2.5kg |
| CM1055A | CHROMOGENIC ENTEROBACTER SAKAZAKII AGAR | 100g |
| CM1055B | CHROMOGENIC ENTEROBACTER SAKAZAKII AGAR | 500g |
| CM1061B | XLT-4 AGAR | 500g |
| CM1061T | XLT-4 AGAR | 5kg |
| CM1065B | COLD FILTERABLE TRYPTONE SOYA BROTH 500GRAMS | 500g |
| CM1065K | COLD FILTERABLE TRYPTONE SOYA BROTH 25KILOS | 25kg |
| CM1065R | COLD FILTERABLE TRYPTONE SOYA BROTH 2.5KILOS | 2.5kg |
| CM1065T | COLD FILTERABLE TRYPTONE SOYA BROTH 5KILOS | 5kg |
| CM1066B | ONE BROTH BASE | 500g |
| CM1066R | ONE BROTH BASE - LISTERIA | 2.5kg |
| CM1079B | TERGITOL 7 BROTH 500G | 500g |
| CM1080B | CHROMOGENIC LISTERIA AGAR BASE | 500g |
| CM1080E | CHROMOGENIC LISTERIA AGAR BASE | 2L PACK |
| CM1081B | DESOXYCHOLATE LACTOSE AGAR (SPECIAL) | 500g |
| CM1082B | VIOLET RED BILE GLUCOSE AGAR (ISO) | 500g |
| CM1084B | CHROMOGENIC LISTERIA AGAR BASE (ISO) | 500g |
| CM1086B | BOUILLON de BASE FRASER 500g | 500g |
| CM1086T | BOUILLON de BASE FRASER 5kg | 5kg |
| CM1091B | ONE BROTH SALMONELLA | 500g |
| CM1091T | ONE BROTH SALMONELLA 5kg | 5kg |
| CM1092B | SALMONELLA CHROMOGENIC MEDIUM MARK 11 | 500g |
| CM1092E | SALMONELLA CHROMOGENIC MEDIUM MARK 11 | 2L Pack |
| CM1105R | 2-YT BROTH | 2.5kg |
| CM1106B | CHROMOGENIC UTI CLARITY AGAR | 500g |
| CM1107B | 24 LEB BASE | 500g |
| CM1107T | 24 LEB BASE | 5kg |
| CM1112B | MSRV (ISO) | 500g |
| CM1114T | MODIFIED SELECTIVE E.coli/coliform AGAR | 5kg |
| CM1115B | EE BROTH-MOSSEL (EP/USP/JP/BP) | 500g |
| CM1117B | ALKALINE PEPTONE WATER (ISO) | 500g |
| CM1121B | CRONOBACTER SCREENING BROTH (CSB) | 500g |
| CM1122B | CCI AGAR BASE | 500g |
本产品详情页介绍里面出现*或X代表有网络不能使用的词汇,如需详细的说明请联系本店客服。
风险提示:丁香通仅作为第三方平台,为商家信息发布提供平台空间。用户咨询产品时请注意保护个人信息及财产安全,合理判断,谨慎选购商品,商家和用户对交易行为负责。对于医疗器械类产品,请先查证核实企业经营资质和医疗器械产品注册证情况。
 技术资料
技术资料暂无技术资料 索取技术资料
Oxoid山梨醇麦康凯琼脂CM0813B,CM0981B,改良TSB CM0989B,EC肉汤CM0853B等
询价









